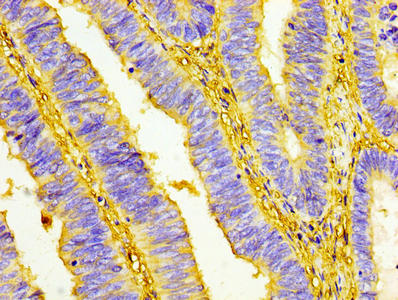

-
中文名稱:UCP1兔多克隆抗體
-
貨號:CSB-PA025554LA01HU
-
規格:¥440
-
圖片:
-
IHC image of CSB-PA025554LA01HU diluted at 1:100 and staining in paraffin-embedded human colon cancer performed on a Leica BondTM system. After dewaxing and hydration, antigen retrieval was mediated by high pressure in a citrate buffer (pH 6.0). Section was blocked with 10% normal goat serum 30min at RT. Then primary antibody (1% BSA) was incubated at 4°C overnight. The primary is detected by a biotinylated secondary antibody and visualized using an HRP conjugated SP system.
-
IHC image of CSB-PA025554LA01HU diluted at 1:100 and staining in paraffin-embedded human breast cancer performed on a Leica BondTM system. After dewaxing and hydration, antigen retrieval was mediated by high pressure in a citrate buffer (pH 6.0). Section was blocked with 10% normal goat serum 30min at RT. Then primary antibody (1% BSA) was incubated at 4°C overnight. The primary is detected by a biotinylated secondary antibody and visualized using an HRP conjugated SP system.
-
-
其他:
產品詳情
-
產品名稱:Rabbit anti-Homo sapiens (Human) UCP1 Polyclonal antibody
-
Uniprot No.:
-
基因名:
-
別名:mitochondrial brown fat uncoupling protein antibody; Mitochondrial brown fat uncoupling protein 1 antibody; SLC25A7 antibody; Solute carrier family 25 member 7 antibody; Thermogenin antibody; UCP 1 antibody; UCP antibody; UCP1 antibody; UCP1_HUMAN antibody; uncoupling protein 1 (mitochondrial, proton carrier) antibody; Uncoupling protein 1 antibody
-
宿主:Rabbit
-
反應種屬:Human
-
免疫原:Recombinant Human Mitochondrial brown fat uncoupling protein 1 protein (2-307AA)
-
免疫原種屬:Homo sapiens (Human)
-
標記方式:Non-conjugated
本頁面中的產品,UCP1 Antibody (CSB-PA025554LA01HU),的標記方式是Non-conjugated。對于UCP1 Antibody,我們還提供其他標記。見下表:
-
克隆類型:Polyclonal
-
抗體亞型:IgG
-
純化方式:>95%, Protein G purified
-
濃度:It differs from different batches. Please contact us to confirm it.
-
保存緩沖液:Preservative: 0.03% Proclin 300
Constituents: 50% Glycerol, 0.01M PBS, PH 7.4 -
產品提供形式:Liquid
-
應用范圍:ELISA, IHC
-
推薦稀釋比:
Application Recommended Dilution IHC 1:20-1:200 -
Protocols:
-
儲存條件:Upon receipt, store at -20°C or -80°C. Avoid repeated freeze.
-
貨期:Basically, we can dispatch the products out in 1-3 working days after receiving your orders. Delivery time maybe differs from different purchasing way or location, please kindly consult your local distributors for specific delivery time.
-
用途:For Research Use Only. Not for use in diagnostic or therapeutic procedures.
引用文獻
- Microglia Sirt6 modulates transcriptional activity of NRF2 to defend high fat diet-induced obesity X Xiao,ResearchSquare,2022
相關產品
靶點詳情
-
功能:Mitochondrial protein responsible for thermogenic respiration, a specialized capacity of brown adipose tissue and beige fat that participates in non-shivering adaptive thermogenesis to temperature and diet variations and more generally to the regulation of energy balance. Functions as a long-chain fatty acid/LCFA and proton symporter, simultaneously transporting one LCFA and one proton through the inner mitochondrial membrane. However, LCFAs remaining associated with the transporter via their hydrophobic tails, it results in an apparent transport of protons activated by LCFAs. Thereby, dissipates the mitochondrial proton gradient and converts the energy of substrate oxydation into heat instead of ATP. Regulates the production of reactive oxygen species/ROS by mitochondria.
-
基因功能參考文獻:
- Results suggest that G-quadruplex structure is a potential target to regulate the expression of uncoupling protein 1 (UCP1). PMID: 29796650
- Cellular and genetic evidence supported the regulation of UCP1 transcription by IRX3 as a direct mechanism on the browning program of white adipocytes. PMID: 28988979
- Multiple regression analysis showed that age, male gender, body max index, presence of obesity, type-2-diabetes mellitus, hypertension and coronary artery disease and left ventricular ejection fraction were associated with the expression levels of UCP1, PGC1alpha and PRDM16 mRNA PMID: 28824327
- Results found a specific fatty acids binding site that is functionally important to the H+ transport activity of UCP1-mediated flux. PMID: 28781081
- MKK6 acts as a repressor of UCP1 expression, suggesting that its inhibition promotes adipose tissue browning and increases organismal energy expenditure. PMID: 29021624
- determined transcriptional levels of UCP1 and UCP2 in peripheral blood mononuclear cells (PBMCs) from patients with metabolic disorders: type 2 diabetes, obesity and from healthy individuals. PMID: 29151065
- We observed that clozapine but not six other antipsychotic drugs reprogrammed the gene expression pattern of differentiating human adipocytes ex vivo, leading to an elevated expression of the browning marker gene UCP1, more and smaller lipid droplets and more mitochondrial DNA than in the untreated white adipocytes. PMID: 27898069
- The GG genotype of the UCP1-3826 A/G polymorphism appears to contribute to the onset of childhood obesity in Turkish children. The GG genotype of UCP1, together with the del/del genotype of the UCP2 polymorphism, may increase the risk of obesity with synergistic effects. The ins allele of the UCP2 exon 8 del/ins polymorphism may contribute to low HDL cholesterolemia. PMID: 28704105
- TENM2 knockdown induces both UCP1 mRNA and protein expression upon adipogenic differentiation without affecting mitochondrial mass. PMID: 28088466
- The role of UCP1 gene polymorphisms A-3826G, A-1766G, Met229Leu and Ala64Thr in susceptibility to obesity or metabolic syndrome was reviewed. PMID: 28100847
- Haplotype-based interaction between the PPARGC1A and UCP1 genes is associated with impaired fasting glucose (IFG) or type 2 diabetes mellitus (T2DM) among the residents of Henan province, China. Individuals with the haplotype AAG (PPARGC1A gene) and CTCG (UCP1 gene) have increased susceptibility to IFG or T2DM, while those with haplotype AAG (PPARGC1A gene) and CTCA (UCP1 gene) have a lower risk of IFG or T2DM. PMID: 28591028
- human and rodent Brown adipose tissue have similar UCP1 function per mitochondrion. PMID: 27508873
- glucocorticoids increased isoprenaline-stimulated respiration and UCP-1 in human primary brown adipocytes. PMID: 27411014
- These results reveal different characteristics in the biological actions between WAT and BAT in obese humans. Increased levels of IL6, UCP1 and SIRT1 in the BAT were associated with metabolic parameters improvements. PMID: 28073126
- UCP1 dietary activation can alleviate obesity. (Review) PMID: 28057582
- The molecular features of UCP1 support a conventional mitochondrial carrier-like mechanism. (Review) PMID: 28057583
- The history of discovery of UCP1, the mitochondrial uncoupling protein of brown adipocyte, has been described. (Review) PMID: 27916641
- Transcriptional regulation of the UCP1 protein in obesity and normal thermogenesis has been described. (Review) PMID: 27693079
- The H+ transport mediated by UCP1 was shown to be electrophoretic with a linear relation to the membrane potential. (Review) PMID: 27794497
- In the absence of purine nucleotides, UCP1 presents a high ohmic proton conductance that does not require the presence of activating ligands, such as fatty acids or retinoids. PMID: 27750036
- UCP1 is a transporter for H(+) and fatty acid anions. (Review) PMID: 27984203
- In inguinal white adipose tissue (iWAT) of mice fed a high-fat diet (HFD), Ucp1 level decreases concomitantly with increases in Cnot7 and its interacting partner Tob. PMID: 26711342
- Findings suggest that polymorphisms in SIRT6/UCP1 genes may be important for increased carotid plaque burden and echodensity PMID: 26332421
- UCP1 -3826 A>G polymorphism is associated with weight, body fat mass, and risk of type 2 diabetes mellitus in obese individuals candidates for bariatric surgery. PMID: 26458326
- UCP1 and UCP3 expression is associated with lipid and carbohydrate oxidation in patients submitted to bariatric surgery. PMID: 26959981
- 1-3826 A>G polymorphism associated with elevated lipid and apolipoprotein levels in Chinese population PMID: 25928572
- this study reveals that human adipose-derived stromal/progenitor cells can be readily differentiated into beige adipocytes that, upon activation, undergo uncoupling protein 1-dependent thermogenesis. PMID: 25389910
- This study suggests that the SNP rs1800592 in the UCP1 gene is associated with increased risk of PDR in the Chinese type 2 diabetes mellitus population. PMID: 25274455
- Genotype and allele distributions of UCP1, UCP2 and UCP3 polymorphisms did not differ significantly between obese and non-obese Type 2 Diabetes Mellitus patients.[Meta-analysis] PMID: 24752406
- Uncoupling protein 1 binds one nucleotide per monomer and is stabilized by tightly bound cardiolipin. PMID: 26038550
- Meta-analysis. There was no significant association of the UCP1-3826A/G polymorphism with BMI mean differences. PMID: 24804925
- By the application of these findings, we demonstrate that UCP1 is functionally thermogenic in intact brite adipocytes and adrenergic UCP1 activation is largely dependent on adipose triglyceride lipase (ATGL) rather than hormone sensitive lipase (HSL). PMID: 25135951
- BMI and TBF were significantly different among UCPI -3826A/G and UCP3 -55C/T genotype combinations, suggesting the existence of a gene interaction between UCP1 and UCP3 in influencing obesity and adiposity in multiethnic Malaysians. PMID: 25812254
- MED1 is required for optimal PRDM16-induced Ucp1 expression PMID: 25644605
- In obesity, in vitro differentiated beige/brite adipocytes derived from preadipocytes of human subcutaneous white adipose tissues express less UCP1. PMID: 24642703
- Human white adipocytes express the cold receptor TRPM8 which activation induces UCP1 expression, mitochondrial activation and heat production. PMID: 24342393
- UCP1 -3826A/G and ADRB3 Trp64Arg polymorphisms may have a combined effect in the modulation of overweight/obesity and HDL-C levels in type 2 diabetes mellitus (T2DM) Caucasian-Brazilian patients PMID: 24138564
- The season-specific effects of UCP1 on visceral fat area were consistent with a previous finding that active brown adipose tissue was more frequently found in winter than in summer. PMID: 24086366
- All-trans-retinoic acid (ATRA) induces UCP1 expression in mouse adipocytes through activation of RARs, whereas expression of UCP1 in human adipocytes is not increased by exposure to ATRA. PMID: 24059847
- VDR directly inhibits the expression of uncoupling protein-1 (UCP1). PMID: 23906633
- UCP1 -3826 A/G substitution accelerates age-related decrease in BAT activity, and thereby may associate with visceral fat accumulation with age. PMID: 23032405
- UCP1 can exist in different functional monomeric and associated states. PMID: 24196960
- UCP-1 is relatively abundant in epicardial fat, and this depot possesses molecular features characteristic of those found in vitro in beige lineage adipocytes. PMID: 23824424
- Compares and contrasts all the known human SLC25A* genes and includes functional information. PMID: 23266187
- High UCP1 expression is associated with pheochromocytoma. PMID: 23454374
- UCP-1 single nucleotide polymorphism A-3826G is associated with the dampness-phlegm pattern in Korean stroke patients. PMID: 23043591
- The present study demonstrates a sex-specific effect of genetic variants in UCP1 and SIRT3 on cIMT PMID: 22750084
- UCP1 in HEK293 cell mitochondria is fully inhibitable and does not contribute to basal proton conductance. PMID: 22676960
- These data are consistent with FTO rs9939609 and UCP-1 rs6536991 common variants as contributors to obesity in the Brazilian population. PMID: 23134754
- This study links the GG homozygous form of UCP1 with obesity and blood pressure among females only. PMID: 22764640
顯示更多
收起更多
-
亞細胞定位:Mitochondrion inner membrane; Multi-pass membrane protein.
-
蛋白家族:Mitochondrial carrier (TC 2.A.29) family
-
組織特異性:Brown adipose tissue.
-
數據庫鏈接:
Most popular with customers
-
-
YWHAB Recombinant Monoclonal Antibody
Applications: ELISA, WB, IHC, IF, FC
Species Reactivity: Human, Mouse, Rat
-
Phospho-YAP1 (S127) Recombinant Monoclonal Antibody
Applications: ELISA, WB, IHC
Species Reactivity: Human
-
-
-
-
-